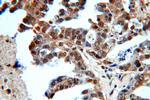
Sestrin 2 Antibody in Immunohistochemistry (Paraffin) (IHC (P))
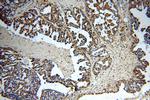
Sestrin 2 Antibody in Immunohistochemistry (Paraffin) (IHC (P))

Search
Proteintech
Sestrin 2 Polyclonal Antibody
{{$productOrderCtrl.translations['antibody.pdp.commerceCard.promotion.promotions']}}
{{$productOrderCtrl.translations['antibody.pdp.commerceCard.promotion.viewpromo']}}
{{$productOrderCtrl.translations['antibody.pdp.commerceCard.promotion.promocode']}}: {{promo.promoCode}} {{promo.promoTitle}} {{promo.promoDescription}}. {{$productOrderCtrl.translations['antibody.pdp.commerceCard.promotion.learnmore']}}
产品信息
10795-1-AP
种属反应
已发表种属
宿主/亚型
分类
类型
抗原
偶联物
形式
浓度
规格
纯化类型
保存液
内含物
保存条件
运输条件
产品详细信息
Immunogen sequence: HMAEFLQTG GDPEWLLGLH RAPEKLRKLS EINKLLAHRP WLITKEHIQA LLKTGEHTWS LAELIQALVL LTHCHSLSSF VFGCGILPEG DADGSPAPQA PTPPSEQSSP PSRDPLNNSG GFESARDVEA LMERMQQLQE SLLRDEGTSQ EEMESRFELE KSESLLVTPS ADILEPSPHP DMLCFVEDPT FGYEDFTRRG AQAPPTFRAQ DYTWEDHGYS LIQRLYPEGG QLLDEKFQAA YSLTYNTIAM HSGVDTSVLR RAIWNYIHCV FGIRYDDYDY GEVNQLLERN LKVYIKTVAC YPEKTTRRMY NLFWRHFRHS EKVHVNLLLL EARMQAALLY ALRAITRYMT (132-480 aa encoded by BC013304)
靶标信息
This gene encodes a member of the sestrin family of PA26-related proteins. The encoded protein may function in the regulation of cell growth and survival. This protein may be involved in cellular response to different stress conditions.
仅用于科研。不用于诊断过程。未经明确授权不得转售。
生物信息学
蛋白别名: Hi95; hypoxia-responsive p53 target; hypoxia induced gene 95; hypoxia-induced; Hypoxia-induced gene; Sestrin-2; unnamed protein product
基因别名: HI95; RGD1566319; SES2; SESN2; SEST2
UniProt ID: (Human) P58004, (Mouse) P58043
Entrez Gene ID: (Human) 83667, (Rat) 502988, (Mouse) 230784